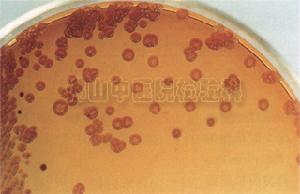
萘啶酸

藥物名稱
 萘啶酸結構式
萘啶酸結構式萘啶酸,通用名:萘啶酸片
化學名 7-甲基-1-乙基-4-氧代-1,4-二氫-1,8-萘啶-3-羧酸
拼音名 NAIDINGSUAN
英文名 NALIDIXICACID
分子式 C12H12N2O3
分子量 232.24
適應症
本品適用於敏感革蘭陰性桿菌所致的尿路感染,如大腸埃希菌、克雷伯菌屬、變形桿菌屬、腸桿菌屬等。由於目前大腸埃希菌對其耐藥者多見,宜根據藥敏結果選用該藥。主要用於敏感菌所致的泌尿系統感染(如膀胱炎、腎盂腎炎)及腸道、膽道感染等的治療,已被同類藥物替代。
藥理毒理
培養皿中的單胞均屬
培養皿中的單胞均屬本品為第一代喹諾酮類抗菌藥,對大腸埃希菌、克雷伯菌屬、變形桿菌屬、志賀菌屬、沙門菌屬、腸桿菌屬及流感嗜血桿菌的部分菌株具抗菌活性,對淋病奈瑟菌亦具抗菌活性,但對假單胞菌屬、不動桿菌屬和葡萄球菌屬等革蘭陽性球菌均無抗菌活性。本品為殺菌劑,尿液pH值變化對其作用無影響。
藥代動力學
口服後自胃腸道迅速吸收,部分在肝臟代謝成為具抗菌活性的與萘啶酸相仿的羥化萘啶酸並經腎臟快速排泄。本品以原型及代謝物經尿排泄。其他代謝物包括與萘啶酸、羥化萘啶酸結合的葡萄糖醛酸及二羧酸衍生物。羥化萘啶酸占血液中藥物生物學活性的30%,尿液中活性的85%。
 與藥物結合的血漿蛋白
與藥物結合的血漿蛋白口服1g後2小時在血漿中的峰濃度為20~50mg/L,血消除半衰期(t1/2?)約1~2.5小時。萘啶酸的血漿蛋白結合率為93%,羥化萘啶酸的血漿蛋白結合率為63%。給藥後3~4小時尿液中的峰濃度(Cmax)為150~200mg/L,t1/2約6小時。本品約4%經糞便排泄,也可從乳汁中分泌。本品可透過胎盤屏障。
用法用量
成人劑量為每次0.5~1g,每日3次,療程1~2周。
不良反應
1.胃腸道反應:噁心、嘔吐、腹瀉、腹痛。
 藥物過敏導致的局部紅疹
藥物過敏導致的局部紅疹2.中樞神經系統反應:嗜睡、無力、頭痛、頭昏及眩暈。
3.過敏反應:皮疹、瘙癢、蕁麻疹、血管性水腫、嗜酸性粒細胞增多、關節痛伴關節強直及腫脹等過敏樣反應。直接暴露於陽光可發生光敏反應。
4.其他:罕見膽汁淤積、感覺異常、代謝性酸中毒、血小板減少、粒細胞減少或溶血性貧血。
禁忌症
對本品過敏及有抽搐病史的患者禁用。
注意事項
 藥物引起的中度光過敏
藥物引起的中度光過敏1.肝臟疾患、腎功能不全、癲癇及嚴重腦動脈硬化患者慎用本品。
2.本品應與飲食同服,適量飲水,不宜同服抗酸藥。
3.服用本品時可發生中、重度光敏反應,應避免過度暴露於陽光,如發生光敏反應需停藥。
4.葡萄糖-6-磷酸脫氫酶(G-6PD)缺乏患者服用本品,偶可發生溶血反應。
5.連續服用本品超過2周者應監測血象、肝、腎功能。
用藥說明
妊娠期用藥當本品劑量達到人用量的6倍時,對大鼠具致畸作用。本品4倍於臨床劑量時可延長妊娠期。然而,對孕婦並未進行適當的、有良好對照的研究。由於本品與其他喹諾酮類藥物一樣可導致未成熟動物關節軟骨損害,不宜用於孕婦。本品可經乳汁分泌,且由於該類藥物對新生兒、嬰幼兒具有潛在的嚴重不良作用的可能性,乳母應避免套用本品或於套用時停止哺乳。兒童用藥本品在3個月以下嬰兒的安全性及有效性尚未確定。毒性研究顯示本品及相關藥物可導致絕大多數受試的未成熟動物負重關節軟骨損害及其他關節病變。因此,本品不宜用於18歲以下青少年及小兒。
老年患者用藥
老年患者常有腎功能減退,因本品主要經腎排出,需減量套用。
藥物相互作用
 不宜與氨茶鹼針劑合用
不宜與氨茶鹼針劑合用1.本品與茶鹼類合用時可導致後者血藥濃度升高,出現茶鹼的不良反應。故合用時應監測茶鹼類血藥濃度並調整給藥劑量。
2.本品干擾咖啡因的代謝,可導致咖啡因清除減少,血漿t1/2β延長。
3.本品與抗凝藥華法林合用時可增強後者的抗凝作用,合用時應嚴密監測患者的凝血酶原時間。
4.本品不宜與呋喃妥因合用,兩者相互拮抗。
5.多種維生素,或其他含鐵、鋅離子製劑及含鋁或鎂的制酸藥可減少本品的口服吸收,導致尿液濃度減低,不得同時服用,不能避免時與服本品間隔至少2小時。
6.與環孢素合用,可使其血藥濃度升高,必須監測環孢素血濃度,並調整劑量。
7.與美法侖合用時會增加胃腸道毒性。
藥物過量
過量服用本品可能會發生精神異常、驚厥、顱內壓增高、代謝性酸中毒、噁心、嘔吐及昏睡。由於藥物快速排泄,反應持續時間較短(2~3小時),如早期發現藥物過量,應進行催吐或洗胃促使胃排空,如藥物已經吸收可增加補液量加速排泄,仔細觀察病情變化,予以對症處理及支持療法。
藥物檢查
 碳酸鈉粉劑
碳酸鈉粉劑溶液的澄清度取本品1.0g,加碳酸鈉試液10ml溶解後,溶液應澄清。乾燥失重取本品,在105℃乾燥至恆重,減失重量不得過0.5%(附錄ⅧL)。熾灼殘渣取本品1.0g,依法檢查(附錄ⅧN),遺留殘渣不得過0.2%。重金屬取熾灼殘渣項下遺留的殘渣,依法檢查(附錄ⅧH第二法),含重金屬不得過百萬分之二十。
藥品鑑別
(1)取本品約10mg,加水1ml與硫酸1ml溶解後,加香草醛約10mg,加熱煮沸2分鐘,溶液由黃色轉變為紅色,並析出黃色沉澱。
(2)取本品,加0.4%氫氧化鈉溶液製成每1ml中含5μg的溶液,照分光光度法(附錄ⅣA)測定,在258與332nm的波長處有最大吸收。
含量測定
取本品約0.3g,精密稱定,置具塞錐形瓶中,精密加氫氧化鈉滴定液(0.1mol/L)25ml,密塞,振搖使溶解,加酚酞指示液數滴,用鹽酸滴定液(0.1mol/L)滴定,並將滴定的結果用空白試驗校正。每1ml的氫氧化鈉滴定液(0.1mol/L)相當於23.22mg的C12H12N2O3。
腎盂腎炎治療案例
 腎盂腎炎
腎盂腎炎腎盂腎炎(pyelonephritis)是指腎臟盂的炎症,大都由細菌感染引起,一般伴下泌尿道炎症,臨床上不易嚴格區分。根據臨床病程及疾病,腎盂腎炎可分為急性及慢性兩期,慢性腎盂腎炎是導致慢性腎功能不全的重要原因。西醫界推薦使用抗生素進行腎盂腎炎的輔助治療,青黴素類藥物:青黴素V、氨苄青黴素、氯黴素以及阿米卡星。以及喹諾酮類藥物,比如萘啶酸類。
病理改變
急性腎盂腎炎病變可為單側或雙側,局限或廣泛,可輕可重,輕者僅累及腎盂黏膜。重者腎臟腫大,切面可見黏膜充血潰瘍,小膿腫形成。如伴梗阻,則腎盞增寬,少數嚴重患者,其腎乳頭及錐體部可見壞死,壞死組織隨尿液排出稱壞死性乳頭炎,鏡下可見腎間質水腫,嗜中性粒細胞浸潤。 慢性腎盂腎炎腎盂及腎盞有慢性炎症表現。腎盂擴大、畸形,腎皮質及乳頭部有瘢痕形成,腎臟較正常縮小,兩側病變常不對稱,腎髓質變形,腎盂腎盞黏膜及輸尿管管壁增蚅,嚴重者腎實質廣泛萎縮。
臨床表現
(一)急性腎盂腎炎 本病可發生於各種年齡,但以育齡婦女最多見,起病爭驟,主要有下列症狀。 1.一般症狀 高熱、寒戰,體溫多在38~39℃之間,也可高達40℃。熱型不一,一般呈弛張型,也可呈間歇或稽留型。伴頭痛、全身酸痛,熱退時可朋大汗等。
2.泌尿系症狀 患者有腰痛,多為鈍痛或酸痛,程度不一,少數有腹部絞能,沿輸輸尿管向膀胱方向放射,體檢時在上輸尿管點(腹直肌外緣與臍平線交叉點)或肋腰點(腰大肌外緣與十二肋交叉點)有壓痛,腎叩痛陽性。患者常有尿頻、尿急、尿痛等膀胱刺激症狀,在上午性感染時,可先於全身症狀出現。兒童患者的泌尿系系症狀常不明顯,起病時除高熱等全身症狀外,常有驚厥、抽搐發作。
3.胃腸道症狀 可有食欲不振、噁心、嘔吐,個別患者可有中上腹或全腹疼痛。
 腎盂腎炎
腎盂腎炎(二)慢性腎盂腎炎 症狀較急性期輕,有時可表現為無症狀性尿。半數以上患者有急性腎盂腎炎既往史,其後有乏力、低熱、厭食及腰酸腰痛等症狀,並伴有尿頻、尿急、尿痛等下尿路刺激症狀。急性發作表現也時出現。以往將病程超過半年或1年者樂為慢性腎盂腎炎,近年來提出腎盂腎盞有瘢痕形成,靜脈腎盂造影見到腎盂腎盞變形、積水、腎外形不光滑,或二腎大小不等才稱慢性腎盂腎炎。可有腎小管功能損害,如濃縮功能減退,低滲、低比重尿,夜尿增多及腎小管性酸中毒等。至晚期,可出現腎小球功能損害,氮質血症直至尿毒症。腎性高血壓很多由慢性腎盂炎引起,一般認為患者高腎素血症及一些縮血管多肽的釋放和血管硬化、狹窄等病變有關。少數患者切除一側病腎後,高血壓得以改善。
慢性腎盂腎炎時臨床表現複雜,容易反覆發作,其原因為:①誘發因素的存在;②腎盂腎盞黏膜、腎乳頭部因瘢痕變形,有利於致病菌潛伏;③長期使用抗生素後,細菌產生了耐藥性,或進入細胞內,使抗生素失去殺菌能力;④在體液免疫或抗生素作用下,細菌胞膜不能形成,以原漿質形式存在,在髓質滲環境下仍有生命力,故一旦環境有利,重新生長胸膜並繁殖再毒辣,此即原漿型菌株(L型)。所以,慢性腎盂腎炎被認為是較難根治而逐漸進展的疾病。
治療措施
(一)一般治療
目的在於緩解症狀,防止復發,減少腎實質的損害。應鼓勵患者多飲水,勤排尿,以降低髓質滲透壓,提高機體吞噬細胞功能,沖洗掉膀胱內的細胞。 通常應鼓勵患者多飲水、勤排尿,以降低髓質滲透壓,提高機體吞噬細胞功能。有發熱等全身感染症狀應臥床休息。服用碳酸氫鈉1g,每日3次,可鹼化尿液,減輕膀胱刺激刺激症狀,並對氨基糖甙類抗生素、青黴素、紅黴素及磺胺、萘啶酸等有增強療效作用,但可使四環素、呋喃咀啶的藥效下降。有誘發因素者應治療,如腎結石、輸尿管畸形等。抗感染治療最好在尿細菌培養及藥物敏感試驗下進行。
(二)抗感染治療
 腎盂腎炎
腎盂腎炎1.急性腎盂腎炎 因引起尿路感染的主要細菌是革蘭陰性菌,其中以大腸桿菌為主。初發的急性腎盂明炎可選用複方磺胺甲惡唑(SMZ-TMP)2片,日2次,或吡哌酸0.5g,日3~4次,諾氟沙星0.2g,日3次,療程7~14天。感染嚴重有敗血症者宜靜脈給藥。根據尿培養結果選用敏感藥物。如頭孢哌酮,阿米卡星毒素對葡萄球菌、克雷伯菌、變形桿菌,綠膿桿菌、大腸桿菌的敏感率均在90%以上。前者1~2g,每8~12小時1次,後者0.4g,每8~12小時1次。氟喹諾酮類藥物對變形桿菌、枸櫞酸桿菌及克雷伯菌敏感率在80%以上。哌拉西林、氨苄西林、呋啁妥因對D群腸球菌100%敏感。用法,前2者1~2,每6時1次;後者0.1g,日3次。真菌感染用酮康唑0.2g,日3次。或氟康唑50mg,日2次。
新生兒,嬰兒和5歲以下的幼兒急性腎盂腎炎多數伴有泌尿道畸形和功能障礙,故不易根除,但有些功能障礙如膀胱輸尿管返流可隨年齡增長而消失。一次性或多次尿感在腎組織中形成局灶性疤痕,甚至影響腎發育,近年來主張用藥前儘可能先做中段尿細胞培養,停藥後第2、4、6周應複查尿培養,以期及時發現和處理。
2.慢性腎盂腎炎 急性發作者按急性腎盂腎炎治療,反覆發作作者應通過尿細菌培養並確定菌型,明確此次再發是復發或重新感染。
復發:指治療後菌株轉陰性,但在停藥後的6周內再發,且致病菌和先前感染的完全相同。復發的常見原因有①尿路解剖上或功能上異常,引起尿流不暢。可通過靜脈腎盂造影或逆行腎盂造影以明確之,如有明顯解剖異常情況存在,需手術加以糾正。如果梗阻因素難以解除,則根據藥敏選用恰當抗菌藥治療6周。②抗菌藥選用不當或劑量和療程不足,常易復發,可按藥敏選擇用藥,治療4周。③由於病變部位瘢痕形成,血流量差,病灶內抗菌藥濃度不足,可試用較大劑量殺菌類型抗菌藥治療如先鋒黴素、氨苄青黴素、羥苄青黴素、乙基因梭黴素等,療程6周。
 腎盂腎炎
腎盂腎炎一年內如尿感發作在3次或3次以上的者又稱復發性尿感,可考慮長程低劑量治療。一般選毒性低的抗菌藥物,如複方磺胺甲噁唑或呋喃坦丁每晚一粒,服用1年或更長,約605患者菌尿轉陰。男性因前列腺炎引起復發者,宜同時治療慢性前列朱炎,選用脂溶性抗菌藥物如複方磺胺甲噁唑;環內沙星0.5g,日2次;利福平0.45~0.6g,頓服,療程宜長達3月。必要時手術切除病變(增生、腫瘤)的前列腺。
如果經兩個療程的足量抗菌治療後,尿菌仍持續陽性,可考慮長程低劑量治療。一般採用複方新諾明或呋喃叮每晚一次,可以服用1年或更長,約60%患者菌轉陰。
再感染:指菌尿轉陰後,另一種與先前不同的致病菌侵入尿路引起的感染,一般在菌尿轉陰6周后再發。婦女的尿感再發,85%是重新感染,可按首次發作的治療方法處理,並囑患患者重視尿感的預防。同時應全面檢查,有無易感因素存在,予以去除。

